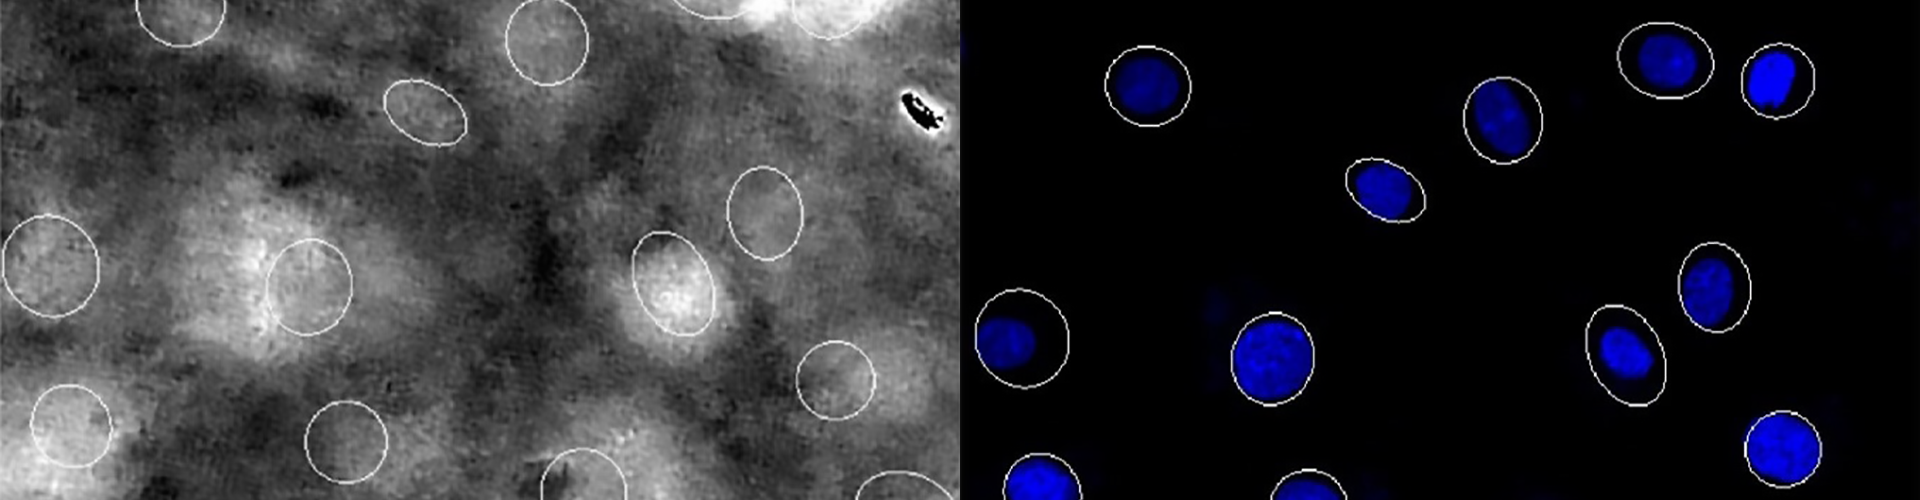
Small highlighted circles in grayscale indicate nuclei segmentation, next to bright blue circles in a similar location showing nuclei location after live-staining.

Precision robotics offers hope for heart disease treatment
Summary:
The advanced drug testing system screens multiple potential therapies simultaneously in beating heart cells.
“This technology will allow us to get the right drug, to the right person, at the right time.”
Dr. Jason Maynes
Chief of the Department of Anesthesia and Pain Medicine
Associate Chief of Research for Perioperative Services
Senior Scientist in the Molecular Medicine program
An advanced robotic system at The Hospital for Sick Children (SickKids) is changing the way physicians and scientists approach treatments for heart disease.
Arrhythmogenic cardiomyopathy (ACM) is a leading cause of sudden cardiac death among young adults. Without any treatment, a heart transplant remains the only curative option for those living with the inherited condition.
Now, a research team led by Dr. Jason Maynes at SickKids and Drs. Yu Sun and Xinyu Liu from the University of Toronto (U of T) Robotics Institute have developed a robotic technology that allows scientists to test numerous potential therapeutics, simultaneously, in this condition for the first time.
Microinjection into beating heart tissue

Technological advancements have contributed to a rise in high-throughput screening (the ability to test a large number of potential therapeutics at once) across a range of health conditions, including oncology. However, unlike cancer cells, scientists studying heart conditions face a unique challenge: three-dimensional (3D) dynamic movement of the heart cells. The movement makes it hard for traditional drug screening technologies to quickly and accurately inject molecules into the beating cardiomyocyte tissue without causing damage to them.
Faced with this challenge, the research team developed a solution – a tiny robot equipped with a special z-shaped micropipette and a 3D imaging system that can insert a fluorescent molecule into drug-treated beating heart cells with speed and precision, allowing scientists to analyze the efficacy of the drug candidates.
Published in Science Robotics, the findings showcase the innovative technology and highlight its potential to revolutionize advanced therapeutics for heart conditions.

"Using this system, our team was able to identify five potential therapies for ACM," says first-author Dr. Wenkun Dou, a postdoctoral fellow at SickKids and U of T. “This type of discovery can only happen when experts from different fields come together.”
With collaborators at the Centro Nacional de Investigaciones Cardiovasculares (CNIC) in Spain, one of the drug candidates was already shown to reduce irregular heartbeats in an ACM preclinical model.
The future of heart treatment
For patients and families affected by ACM, this research holds potential to accelerate the discovery of new treatments and could effectively eliminate the need for invasive heart surgery. But thanks to the personalized approach to high-throughput screening, the research team believes the impacts could echo far beyond ACM as part of SickKids’ vision of Precision Child Health, a movement to deliver individualized care to every patient.
“The ability to model specific patient conditions and test therapies quickly and with high volume means that treatments can be tailored to the individual needs of each patient,” says Maynes.
This study was funded by the Canadian Institutes of Health Research (CIHR), the Natural Sciences and Engineering Research Council of Canada (NSERC), the Ontario Research Fund – Research Excellence program, the Montgomery County Intermediate Unit (MCIU) and SickKids Foundation.
